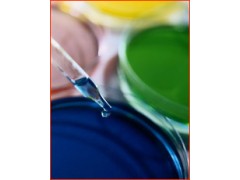

邮箱:xintuo07@163.com MSN:lindalu284@msn.com,欢迎来电咨询
点腐蚀: 《不锈钢三氯化铁点腐蚀试验方法 》GB/T17897-1999
1:试样要求:10c㎡以上,原则为(30-40)*20*(1.5-5)mm
2:试样溶液:用符合GB/T622规定的纯盐酸和蒸馏水或去离子水配成0.0.mol/l,配置成6%三氯化铁溶液。
3:实验步骤:讲配制浓度为6%的三氯化铁溶液倒入试验容器中,每平方厘米试样表面积所需的试验溶液量在20ml以上,将试验容器放入恒温槽中,加热到规定温度,把试样放到溶液中的支架上,连续进行24浸泡(时间可以协商规定),试验结束后,取出试样,清除试样上的腐蚀产物,洗净,干燥后称重。每次试验都要用新的试验溶液。
欢迎来电咨询,无锡信拓还可以检测如下:晶间腐蚀实验如下:
1:《金属和合金的腐蚀 不锈钢晶间腐蚀试验方法》 GB/T 4334-2008
2:《不锈钢5%硫酸腐蚀试验方法》 GB/T 4334.6-2000
3:《煅制高镍铬轴承合金晶间腐蚀敏感性的检查用测试方法》方法A ASTM G28-02(2008)
点腐蚀: 《不锈钢三氯化铁点腐蚀试验方法 》GB/T17897-1999
缝隙腐蚀 《不锈钢三氯化铁缝隙腐蚀试验方法》 GB/T 10127-2002
应力腐蚀
1: 《不锈钢在沸腾氯化镁溶液中应力腐蚀试验方法》YB/T 5362-2006
2: 《金属在硫化氢环境中抗特殊形式环境开裂实验室试验》 GB/T 4157-2006
3: 《金属和合金的腐蚀 应力腐蚀试验》 GB/T 15970.1-1995
4: 《金属和合金的腐蚀 应力腐蚀试验》 第2部分:弯梁试样的制备和应用 GB/T 15970.2-2000
5: 《金属和合金的腐蚀 应力腐蚀试验》 第3部分:U型弯曲试样的制备和应用 GB/T 15970.3-1995 6: 《金属和合金的腐蚀 应力腐蚀试验 第4部分:单轴加载拉伸试样的制备和应用》 GB/T 15970.4-2000
7: 《金属和合金的腐蚀 应力腐蚀试验》 第5部分:C型环试样的制备和应用 GB/T 15970.5-1998
8:《金属和合金的腐蚀 应力腐蚀试验》 第5部分:C型环试样的制备和应用 GB/T 15970.5-1998
9:《金属和合金的腐蚀 应力腐蚀试验》 第6部分:恒载荷或恒位移下的预制裂纹试样的制备和应用 GB/T 15970.6-2007
10:《金属和合金的腐蚀 应力腐蚀试验》 第7部分:慢应变速率试验 GB/T 15970.7-2000
11:《金属和合金的腐蚀 应力腐蚀试验》 第8部分:焊接试样的制备和应用 GB/T 15970.8-2005
12:《焊接性试验-斜Y型坡口焊接裂纹试验方法》 GB/T4675.1-1984